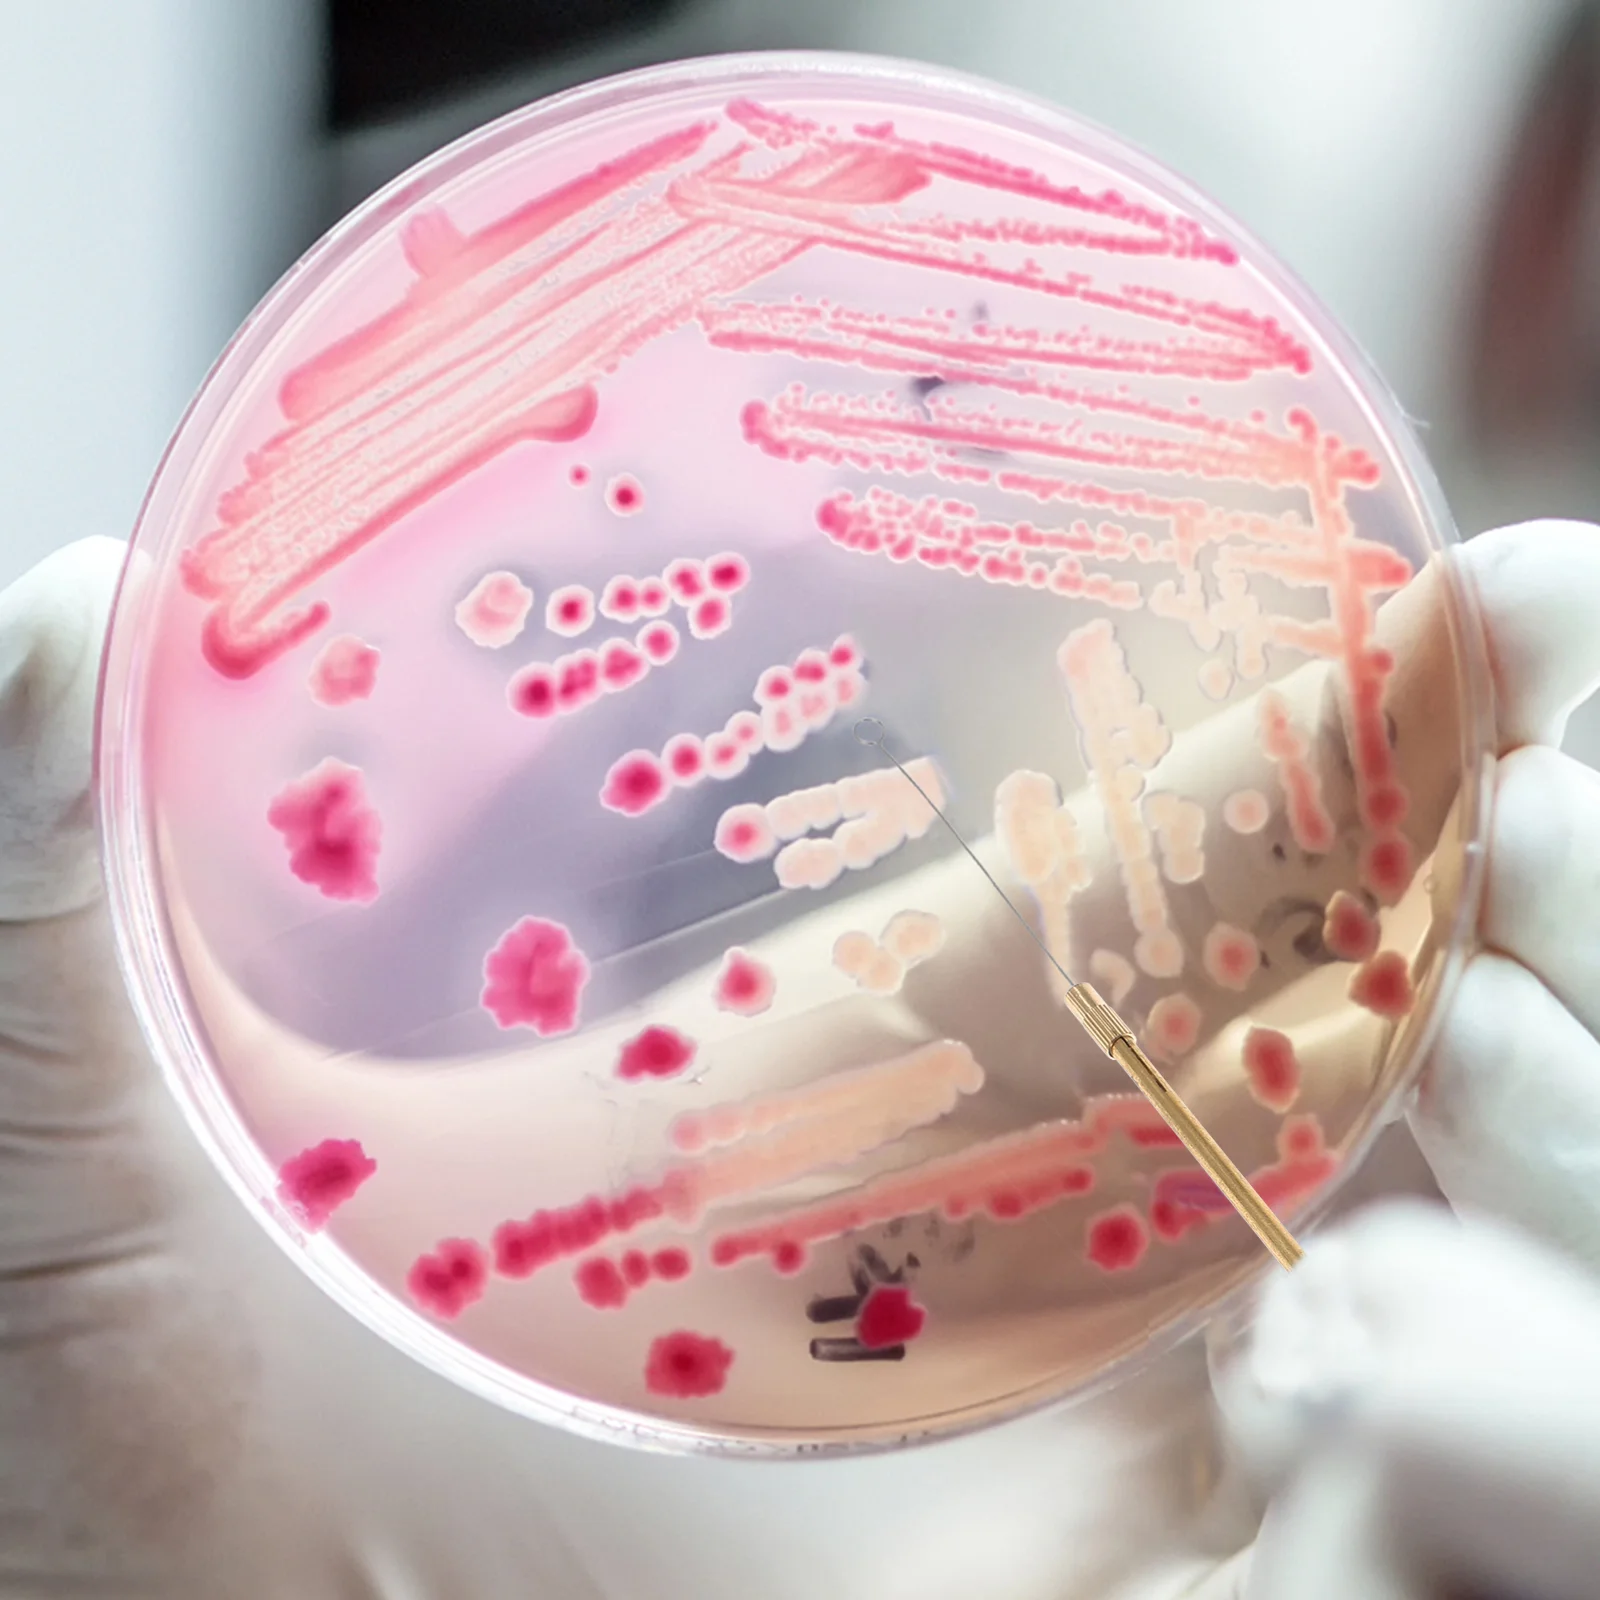
thumb
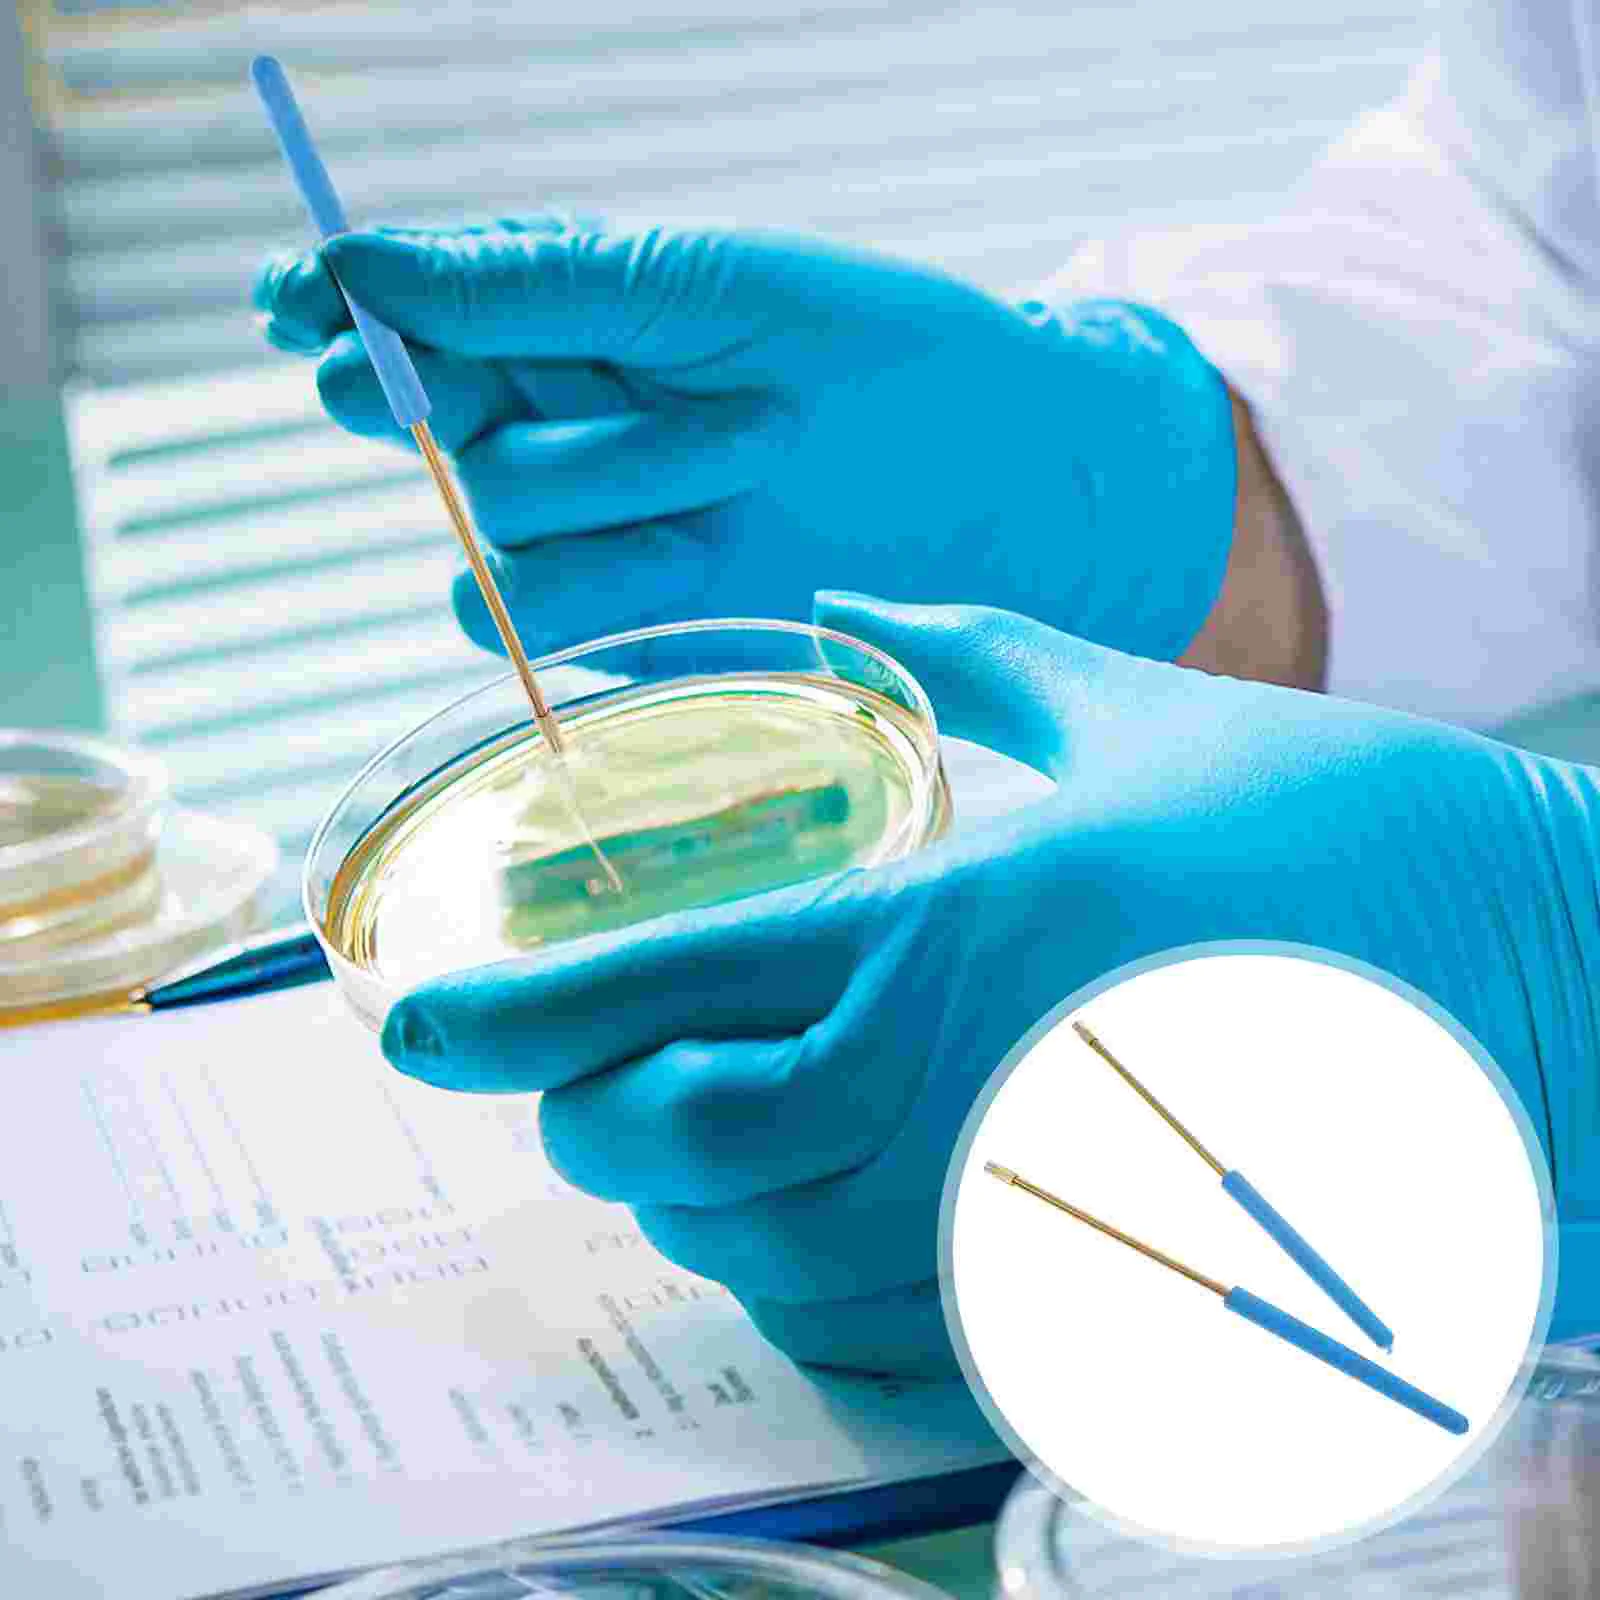
thumb

Микробиологический стержень для инокуляции, лабораторные инструменты, лабораторные детали, лабораторное устройство, игла для инокуляции, кольцо для инокуляции
График изменения цены & курс обмена валют
Пользователи также просматривали

$9.02
European and American trend men's long sleeved standing collar button up shirt printed shirt casual soft and comfortable men's t
aliexpress.com
$1.00
Carrying Folder Holder Fittings Spare Parts Parts Replace Cleaning Tool Storage Rack Supplies Vacuum Cleaner 1pcs
aliexpress.com
$8.89
Сменный топливный разъем 3B2-70260-1 3B2-70250-1, 5/16 дюйма, замена для подвесного 2,4-тактного двигателя Nissan 5-90HP
aliexpress.com
$3.02
Резиновая гайка M5, 5 мм, метрическая гайка для ветрового стекла мотоцикла, латунные гайки
aliexpress.com
$20.69
Diesel Common Rail Injector Nozzle Needle Removal Puller Tool For BOSCH DENSO DELPHI SIMENS CAT
aliexpress.com
$162.00
2pcs Front Shock Absorber Fit for Kia Sorento 2010-2014 / Hyundai Santa Fe 2010-2012 OE#: 546502P100 546502P650 546502P500
aliexpress.com
$37.38
Пижамы, ночные рубашки 2945/2946/2951 WILLIAM Пижама для мальчиков с шортами, Синий, 2945/2946/2951 WILLIAM Пижама для мальчиков с шортами
belpodium.ru
$72.60
S / N: 20008 маленький ручной резьбонарезающий станок с ручным приводом без силовой технологии, микро резьбонарезающий станок
aliexpress.ru
$31.35
Модный новый текстурированный двубортный Блейзер TRAF 2022, Женский Повседневный Блейзер, Женский офисный элегантный женский костюм, куртка
aliexpress.com
$24.66
Клавиатуры, оборудование для набора текста, аксессуары для ноутбука, чувствительная Замена для ноутбука MateBook X Pro MACH-W19C
aliexpress.com
$14.14
Внеклассные книги для 3-го класса, письменные принадлежности для детской литературы, учебные пособия для внеклассного чтения
aliexpress.ru